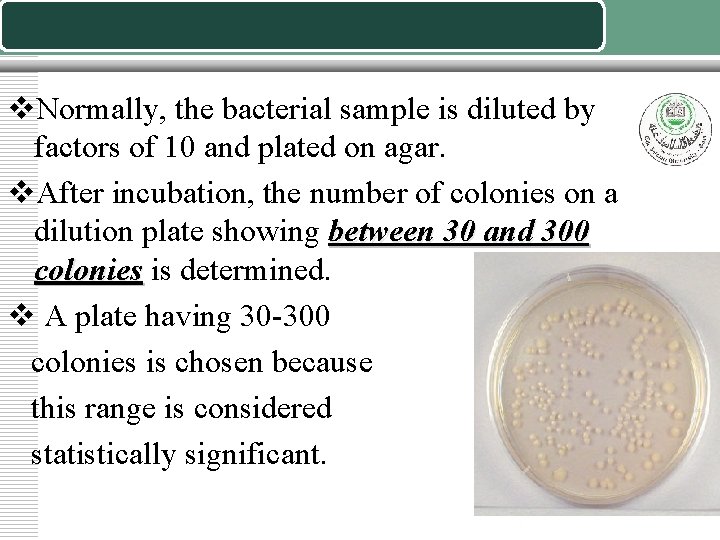
v. Normally, the bacterial sample is diluted by factors of 10 and plated on
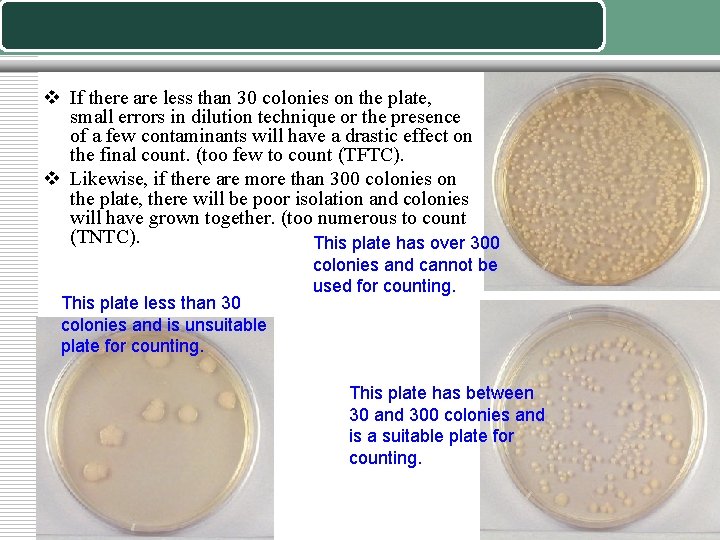
v If there are less than 30 colonies on the plate, small errors in

General Microbiology Laboratory The Serial Dilution Method of

General Microbiology Laboratory The Serial Dilution Method of Bacteria Enumeration

v. Many studies require the quantitative determination of bacterial populations. The two most widely used methods for determining bacterial numbers are: • The standard plate count method. • Spectrophotometer (turbid metric) analysis. v. The standard plate count method is an indirect measurement of cell density ( live bacteria). v. The spectrophotometer analysis is based on turbidity and indirectly measures all bacteria (cell biomass), dead and alive.

The plate count (VIABLE COUNT) v The number of bacteria in a given sample is usually too great to be counted directly. v However, if the sample is serially diluted and then plated out on an agar surface in such a manner that single isolated bacteria form visible isolated colonies, the number of colonies can be used as a measure of the number of viable (living) cells in that known dilution.

v Keep in mind that if the organism normally forms multiple cell arrangements, such as chains, the colony -forming unit may consist of a chain of bacteria rather than a single bacterium. v In addition, some of the bacteria may be clumped together. Therefore, when doing the plate count technique, we generally say we are determining the number of Colony-Forming Units (CFUs) in that known dilution. v By extrapolation, this number can in turn be used to calculate the number of CFUs in the original sample.
v. Normally, the bacterial sample is diluted by factors of 10 and plated on agar. v. After incubation, the number of colonies on a dilution plate showing between 30 and 300 colonies is determined. v A plate having 30 -300 colonies is chosen because this range is considered statistically significant.
v If there are less than 30 colonies on the plate, small errors in dilution technique or the presence of a few contaminants will have a drastic effect on the final count. (too few to count (TFTC). v Likewise, if there are more than 300 colonies on the plate, there will be poor isolation and colonies will have grown together. (too numerous to count (TNTC). This plate has over 300 This plate less than 30 colonies and is unsuitable plate for counting. colonies and cannot be used for counting. This plate has between 30 and 300 colonies and is a suitable plate for counting.

v For a more accurate count it is advisable to plate each dilution in duplicate or triplicate and then find an average count. Fig 1 Fig 2

Counting colonies v At the end of the incubation period, Count by looking at the bottom of the plate (while keeping the Petri plate closed). v Agar is translucent you should not have to open the plate v Select all of the Petri plates containing between 30 and 300 colonies. Count the colonies on each plate. v Plates with more than 300 colonies cannot be counted and are designated too many to count (TMTC). Also we might not have isolated colonies v Plates with fewer than 30 colonies are designated too few to count (TFTC). v If there a lot of colonies on the plate helpful to use a marker to mark the colonies already counted

CFU v Colonies forming units § Not the same as bacteria. § 2 bacteria might have been very close and formed one colony. v Calculate the number of bacteria (CFU) per milliliter or gram of sample by dividing the number of colonies by the dilution factor multiplied by the amount of specimen added to agar plate. v CFU per ml of sample = number of colonies / (amount plated X dilution)

CFU calculation example v. You count 46 colonies on your plate v. You put 1 ml of bacterial culture into 99 ml of saline and plated 0. 1 ml v. Dilution 1/100 v. CFU= 46 1/100 * 0. 1 = 46 * 100 * 10 =46 000

End of lecture
- Slides: 11